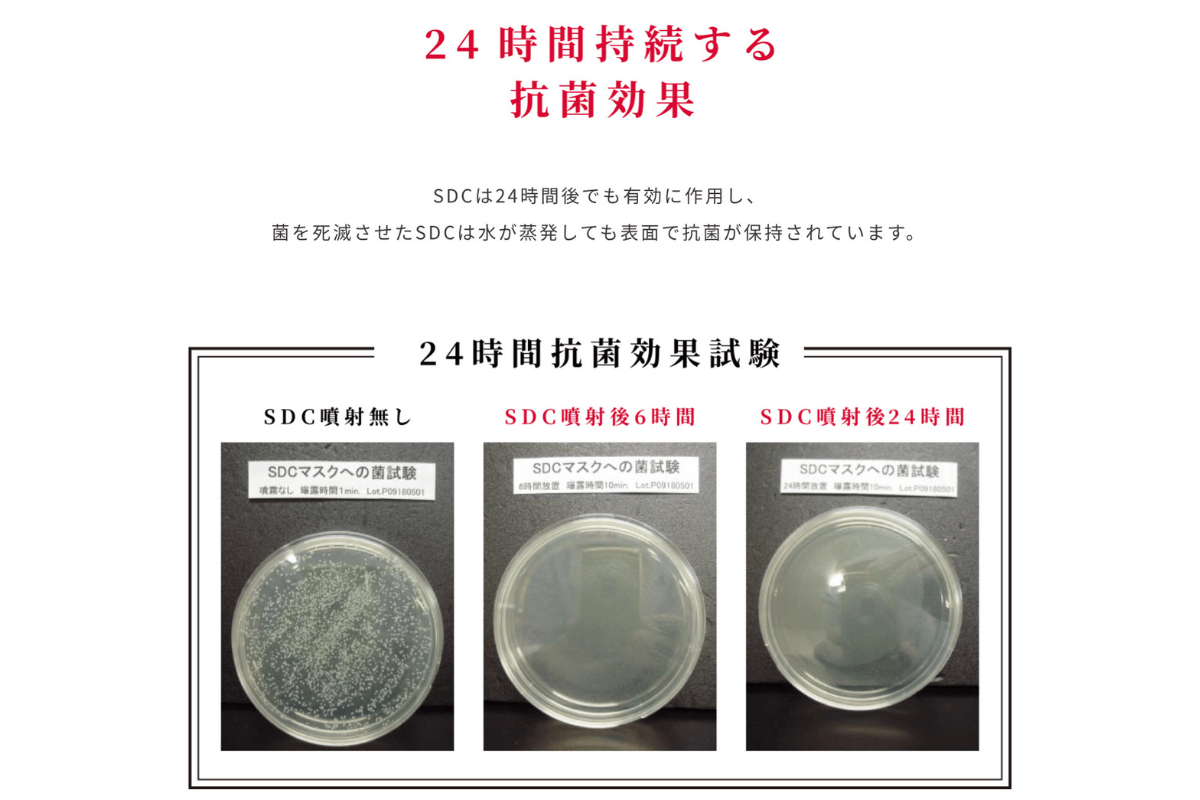

はじめに・ご挨拶
初めまして!アマネサーオハナです。
アマネサー=夜明け
オハナ=家族
代表・大槻は、7年前、12年のエステティシャン経験を経て心と身体を繋ぐトータルヒーリングサロンamanecerを設立しました。
これまでに1万人以上の方のお身体に携わってきました。
その中で身体と心は密接に繋がっていて、その方が本来の健康や美しさを取り戻すためには身体的アプローチと同時に精神的なアプローチも必要だということを感じるようになりました。
そこで、神経を緩めて深いリラックス状態からトリートメントを行い、ご自身が持っている自然治癒力を高め内に秘めている力を引き出すお手伝いをサロンメニューで行っています。

今回こちらに出展しているamanecer ohanaは、私と同じようにエステやネイル、ヘアなど個人サロンの美容関係のオーナー様のコミュニティーを作り、その中でスタッフも使いたい、そしてお客様にも喜んでいただけるような日本にはまだ流通していない、海外の最新のコスメや雑貨を仕入れ、販売している部門です。
サロンでお手入れをして、お客様の心や身体が元気になるのは当たり前!
日常の生活の中でもより良いものを選択し、取り入れて頂くことで健康や豊かさを手に入れることができる。そのお手伝いをしたい!という思いからサロン運営と物販流通事業を行っています。

このプロジェクトで実現したいこと
今回、このプロジェクトで実現したいことは、この【SDC抗菌万能スプレー】を多くの方に知って使って頂きたいということです。


日本初上陸の成分SDCとは↓
プロジェクトをやろうと思った理由
菌やウイルスから身を護るため、消毒は必須になりました。
外出先でも至るところで手指消毒が義務づけられていますが逆に皮膚や身体に負担をかけていることもあるのではないでしょうか?
私はセラピストでお客さまのお体に直接触れることもあり、一日何度も手を洗い
アルコール消毒も必須でしたがそのために手荒れにも悩まされていました。
そんな時に出会ったのがこの
【SDC抗菌万能スプレー】です。
消毒剤の代わりにこちらを使うようになってから、手がしっとりし、手荒れも全く感じなくなりました。
とても不思議だったので商品や成分のことを調べてみたところ、
30種類以上の菌やウイルスに対しての効果があり、アメリカと台湾でも認められているものだと分かり、(全ての菌に効果的ということではありません)同じように手荒れで悩むエステティシャンや美容師の友人にプレゼントをし、とても喜んでもらいました。
世界ではすでに認められている成分(SDC)なのに、日本ではまだ知られていないということに衝撃を受けました。
そこで、私達のような職種の人だけではなく肌の敏感な子供やお年寄りも含め、日本中の皆さんに知って使って頂きたいと思いプロジェクトを決意致しました。

資金の使い道
商品販売スタートまでに、ひと足早く、お届けします。
資金は、皆様へ商品をお届けするための仕入れと送料です。
皆さまに使っていただくため、私達は今回利益は取りません。
リターンについて
SDC抗菌万能スプレーをお届けします。大切な人にプレゼントとしても!


実施スケジュール
4/29まで募集しております。5月より7営業日以内に順次発送して参ります。
最後に
まだ日本では使われていないSDC。
除菌や消毒なんてどれも同じ。そう思われる方もいらっしゃると思います。
私達もそう思っていました。
違いは使ってみたらわかります。
手を使うお仕事・水仕事などの家事・介護や子育てなど・・・
毎日のその消毒や消臭スプレー。肌に負担を与えることをやめませんか?
自分の身を守るのは自分です。
あなたのまわりの大切な存在をまもるのも、あなたです。
どうぞご支援を宜しくお願い致します。
<All-in方式の場合>
本プロジェクトはAll-in方式で実施します。目標金額に満たない場合も、計画を実行し、リターンをお届けします。







コメント
もっと見る